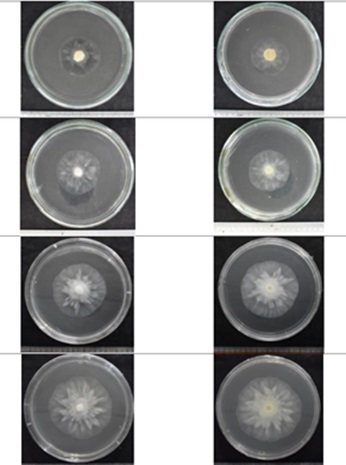

Tổng quan về rau họ cải
Rau họ cải là nhóm rau phổ biến trên toàn thế giới. Chúng có nguồn gốc từ châu Âu và được trồng rộng rãi ở các vùng ôn đới. Đặc điểm nhận dạng của rau họ cải là thân cây thẳng, cao từ 30-60 cm, có nhiều nhánh phân cành, lá có hình dạng khác nhau tùy loại (thường có hình bầu dục), hoa có màu vàng hoặc trắng, có thể mọc thành từng chùm, quả hình dạng dẹt có nhiều hạt nhỏ bên trong. Rau họ cải có nhiều loại khác nhau, bao gồm cải bó xôi, cải thìa, cải xoăn, cải ngọt, cải tía tô và cải cầu vồng. Trong rau cải chứa nhiều chất dinh dưỡng, vitamin và khoáng chất cần thiết cho cơ thể như vitamin A, C, K, axit folic, các khoáng chất như canxi, sắt và kali. Loại rau này có tác dụng giảm cân và giảm nguy cơ mắc bệnh tiểu đường vì trong rau họ cải chứa ít calo và chứa nhiều chất xơ, giúp giảm cảm giác đói và kiểm soát đường huyết. Rau họ cải cũng có tác dụng tốt cho tiêu hóa, giúp giảm nguy cơ mắc các bệnh về đường tiêu hóa.
Rau họ cải khá phổ biến ở Việt Nam vì dễ trồng, thích nghi với điều kiện khí hậu và chi phí đầu tư thấp (vài triệu đồng/công), thời gian thu hoạch nhanh. Tuy nhiên, như bất kỳ loại cây trồng nào khác, rau họ cải dễ bị sâu bệnh gây hại. Một trong những bệnh thường gặp nhất của rau họ cải là bệnh thối nhũn và thối rễ.

Bệnh thối nhũn do vi khuẩn Erwinia carotovora gây ra, còn bệnh thối rễ có nguyên nhân từ nấm Pythiaceae. Những loại nấm và vi khuẩn này có thể sống trong đất và tấn công rễ của cây, gây ra sự suy yếu khiến cây bị chết. Bệnh thối nhũn gây hại trên hầu hết rau họ cải nhưng đặc biệt thường xảy ra trên bắp cải, quá trình bệnh xuất hiện từ đầu bắp rồi lan dần xuống phía dưới hoặc từ gốc phát triển lên trên. Ở lá bắp, vết bệnh lúc đầu có dạng giọt dầu, dần dần biến thành màu nâu nhạt, mô bệnh nhanh chóng lan rộng và thối nhũn, có mùi khó ngửi. Lá ngoài cùng của cây bị héo rũ vào ban ngày, đến ban đêm có thể phục hồi. Nếu bệnh tiếp tục phát triển thì lá không thể phục hồi được, dẫn tới héo rũ, cụp xuống để lộ rõ bộ phận bắp bên trong.
Để phòng ngừa bệnh này, người trồng rau họ cải ngay từ đầu đã phải chọn giống cây khỏe mạnh và trồng cây ở những vùng đất có độ thoát nước tốt. Đồng thời, họ thường sử dụng thuốc bảo vệ thực vật hóa học để giảm thiểu thiệt hại do sâu bệnh, cỏ dại và tăng năng suất. Tuy nhiên, mặt trái của việc sử dụng thuốc bảo vệ hóa học là gây ô nhiễm môi trường, ảnh hưởng đến sức khỏe con người và động vật. Khi sử dụng quá nhiều thuốc bảo vệ hóa học có thể khiến các loài sâu, cỏ hoặc vi khuẩn trở nên kháng lại thuốc và thuốc không còn hiệu quả.
Biện pháp mới phòng chống bệnh thối nhũn, thối rễ trên rau họ cải
Để giải quyết vấn đề thối nhũn, thối rễ trên rau họ cải, mà không phải sử dụng thuốc bảo vệ hóa học, nhóm nghiên cứu thuộc Trung tâm Công nghệ sinh học TP Hồ Chí Minh đã tiến hành khảo sát các vườn rau trên địa bàn một số tỉnh Đông Nam Bộ, Tây Nam Bộ và Tây Nguyên. Qua đó, nhóm nghiên cứu đã thu thập được 32 mẫu rau có triệu chứng bị bệnh. Tất cả đều do vi khuẩn Erwinia carotovora và nấm thuộc họ Pythiaceae gây ra. Nhóm nghiên cứu tiếp tục phân lập ra 5 chủng vi khuẩn thuộc chi Erwinia và 3 chủng được xác định là họ Pythiaceae. Trong 8 chủng vi khuẩn này, chủng nấm RR1 và chủng vi khuẩn SR20 có khả năng gây bệnh mạnh nhất cho cây rau họ cải. Kết quả định danh sinh học cho thấy, 2 chủng này có độ tương đồng 100% với vi khuẩn Erwinia carotovora và Pythiaceae vexans GU133475.1 trong Ngân hàng Gene (NCBI).
Sau khi nghiên cứu được các chủng vi khuẩn có độc tính cao, nhóm nghiên cứu đã tìm ra chủng vi khuẩn Streptomyces spp. có khả năng sản xuất các chất kháng sinh tự nhiên như Streptomycin, Tetracycline và Chloramphenicol, có tác dụng kháng khuẩn và kháng nấm. Khi được sử dụng trong bảo vệ rau họ cải, Streptomyces spp. có thể ngăn chặn sự phát triển của vi khuẩn và nấm gây bệnh, giúp cây trồng phát triển khỏe mạnh và tăng năng suất. Ngoài ra, Streptomyces spp. còn có khả năng sản xuất các chất sinh học có lợi cho cây trồng, giúp tăng cường hệ miễn dịch của cây trồng và giảm thiểu sự tổn thương do bệnh tật. Việc sử dụng Streptomyces spp. trong bảo vệ rau họ cải góp phần giảm thiểu việc sử dụng các loại thuốc trừ sâu và thuốc bảo vệ hóa học có hại cho môi trường và sức khỏe con người.
Hiện nay trên thị trường Việt Nam, các thuốc được chiết dịch từ Streptomyces spp. chủ yếu được nhập từ nước ngoài, chưa có đơn vị nào trong nước sản xuất. Do vậy, nhóm nghiên cứu đã tiến hành chế tạo sản phẩm chiết dịch thứ cấp Streptomyces spp.. Ưu điểm của dịch chiết này là thời gian tác động nhanh, an toàn với người sử dụng và không gây ô nhiễm môi trường, đặc biệt dịch chiết có tác dụng khiến vi khuẩn rơi vào trạng thái ngủ và suy yếu dần.
Từ những ưu điểm của Streptomyces spp., nhóm nghiên cứu đã phân lập thành công 112 chủng Streptomyces spp. từ 81 mẫu đất của 3 vùng Đông Nam Bộ, Tây Nam Bộ và Tây Nguyên. Kết quả thu được 2 chủng gồm LD26 có khả năng sinh hoạt chất kháng Pythiaceae vexans mạnh nhất, đạt 51,87% sau 48 giờ và LD41 có khả năng ức chế vi khuẩn Erwinia carotovora cao hơn các chủng còn lại, đường kính vòng ức chế đạt 5,71 mm. Cuối cùng, nhóm nghiên cứu đã sử dụng dung môi hữu cơ ethyl acetate để tạo ra chế phẩm sinh học cho hai quá trình chiết từ Streptomyces nashvillensis LD41 và Streptomyces filamentosus LD26.
Quá trình định danh hoạt chất kháng bệnh của LD41 và LD26.
Khi nhóm nghiên cứu tiến hành kiểm tra chế phẩm sinh học tạo được trên rau họ cải trong điều kiện phòng thí nghiệm, kết quả cho thấy, rau có màu xanh sáng, các lá có mặt trên bóng, mặt dưới có lông mịn, nhiều lá non phát triển và đặc biệt không còn xuất hiện các vi khuẩn Erwinia carotovora và nấm Pythiaceae vexans. Nếu được ứng dụng rộng rãi trong sản xuất, kết quả nghiên cứu sẽ mang lại nhiều tác động tích cực trên cả hai mặt môi trường và kinh tế, xã hội, cụ thể:
Về môi trường: chế phẩm sinh học được sử dụng từ nguồn gen bản địa nên an toàn, giảm tối đa các nguy cơ mới có thể phát sinh; có tác dụng chống lại các loại sâu bệnh và nấm gây hại cho cây trồng nhưng không gây hại đến các loài côn trùng có ích và các loài động vật khác; có thể thay thế thuốc bảo vệ thực vật hóa học, góp phần bảo vệ môi trường và an toàn với người sử dụng.
Về kinh tế xã hội: chế phẩm sinh học có khả năng giúp tăng năng suất, chất lượng sản phẩm, giảm chi phí sản xuất và tăng thu nhập cho nông dân. Bên cạnh đó, sự an toàn của chế phẩm còn giúp giảm chi phí chăm sóc sức khỏe và tăng chất lượng cuộc sống cho người trồng rau; đồng thời mở ra cơ hội tạo thêm các công việc mới, thúc đẩy sự phát triển kinh tế trong lĩnh vực công nghiệp sinh học.
Có thể thấy, dù còn nhiều việc cần làm, song thành công ban đầu của nhóm nghiên cứu không chỉ mang lại lợi ích về kinh tế, xã hội mà còn có tác dụng bảo tồn, giữ gìn, khai thác hiệu quả thế mạnh các chủng vi sinh vật nội địa tiềm năng ở phía Nam nước ta. Trong thời gian tới, nhóm nghiên cứu sẽ tìm hiểu thêm các phương pháp để tăng hiệu quả tách chiết và cách bảo quản dịch chiết thô nhằm lưu giữ các hoạt chất kháng bệnh lâu nhất.